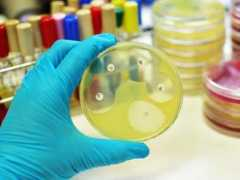
Meryi

First names for Meryi
- Mery Meryi 3
- Meryi Meryi 2
- Meryam Meryi 2
- Merliza Meryi 2
- Maryam Meryi 2
- Heru Meryi 2
- Haya Meryi 2
- Hang Meryi 2
- Hanane Meryi 2
- David Meryi 2
- Yasmine Meryi
- Suru Meryi
- Siri Meryi
- Shannon Meryi
- Sabah Meryi
- Pars Meryi
- Mor Meryi
- Moma Meryi
- Mohamad Meryi
- Mirwa Meryi
- Miimi Meryi
- Mhery Meryi
- Meski Meryi
- Meryimeryi Meryi
- Meryem Meryi
- Merisa Meryi
- Maryem Meryi
- Maryama Meryi
- Mariya Meryi
- Mariam Meryi
- Llala Meryi
- Escalona Meryi
- Eileen Meryi
- Dima Meryi
- Che Meryi
- Ana Meryi
- Abw Meryi
Typos & Misspells
meyri, mreyi, mery, meryia, meryo, meeyi, meryie, meryii, meryioTop Images for Meryi

Similar Names
Meryiem / MeryimSeryi / Merya / Heryi / Merye / Meryo / Meryu / Jeryi / Teryi / Feryi / Deryi